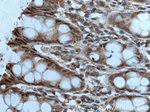
HPGD Antibody in Immunohistochemistry (Paraffin) (IHC (P))

Search
Proteintech
HPGD Monoclonal Antibody (3F1F5)
{{$productOrderCtrl.translations['antibody.pdp.commerceCard.promotion.promotions']}}
{{$productOrderCtrl.translations['antibody.pdp.commerceCard.promotion.viewpromo']}}
{{$productOrderCtrl.translations['antibody.pdp.commerceCard.promotion.promocode']}}: {{promo.promoCode}} {{promo.promoTitle}} {{promo.promoDescription}}. {{$productOrderCtrl.translations['antibody.pdp.commerceCard.promotion.learnmore']}}
产品信息
66798-1-IG
种属反应
宿主/亚型
分类
类型
克隆号
抗原
偶联物
形式
浓度
规格
纯化类型
保存液
内含物
保存条件
运输条件
产品详细信息
Immunogen sequence: MHVNGKVAL VTGAAQGIGR AFAEALLLKG AKVALVDWNL EAGVQCKAAL DEQFEPQKTL FIQCDVADQQ QLRDTFRKVV DHFGRLDILV NNAGVNNEKN WEKTLQINLV SVISGTYLGL DYMSKQNGGE GGIIINMSSL AGLMPVAQQP VYCASKHGIV GFTRSAALAA NLMNSGVRLN AICPGFVNTA ILESIEKEEN MGQYIEYKDH IKDMIKYYGI LDPPLIANGL ITLIEDDALN GAIMKITTSK GIHFQDYDTT PFQAKTQ (1-266 aa encoded by BC018986)
靶标信息
Prostaglandin inactivation. Contributes to the regulation of events that are under the control of prostaglandin levels. Catalyzes the NAD-dependent dehydrogenation of lipoxin A4 to form 15-oxo-lipoxin A4. Inhibits in vivo proliferation of colon cancer cells.
仅用于科研。不用于诊断过程。未经明确授权不得转售。
生物信息学
蛋白别名: 15-hydroxyprostaglandin dehydrogenase (NAD(+)); 15-hydroxyprostaglandin dehydrogenase [NAD(+)]; 15-PGDH; eicosanoid/docosanoid dehydrogenase; Eicosanoid/docosanoid dehydrogenase [NAD(+)]; hydroxyprostaglandin dehydrogenase 15-(NAD); NAD+-dependent 15-hydroxyprostaglandin dehydrogenase; Prostaglandin dehydrogenase 1; Short chain dehydrogenase/reductase family 36C member 1; unnamed protein product
基因别名: 15-PGDH; HPGD; PGDH; PGDH1; PHOAR1; SDR36C1
UniProt ID: (Human) P15428
Entrez Gene ID: (Human) 3248